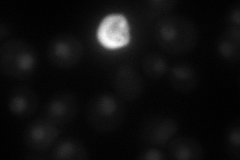
YKL012W
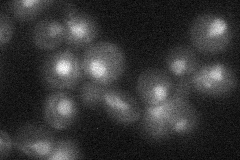
YKL012W
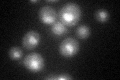
YKL012W

View description
U1 snRNP protein involved in splicing, interacts with the branchpoint-binding protein during the formation of the second commitment complex
Localization:
Intensity:
Fold change:
Significance:
-
C’ GFP library in SD

nucleus23 -
N' NOP1pr-GFP in SD

nucleus61.2045 -
N' TEF2pr-mCherry in SD
nucleus35.5285 -
N' NATIVEpr-GFP in SD
nucleus26.0449 -
N' TEF2pr-VC and Cyto-VN in SD

nucleus31.0285 -
C’ GFP library in SD+DTT
nucleus23.111No -
C’ GFP library in SD+H2O2

nucleus24.471.06No -
C’ GFP library in Starvation Media

nucleus23.231No -
C’ GFP library on the background of Pup2-DaMP

nucleus -
C’ GFP library on the background of CCT mutant

nucleus26.67851.15965No
